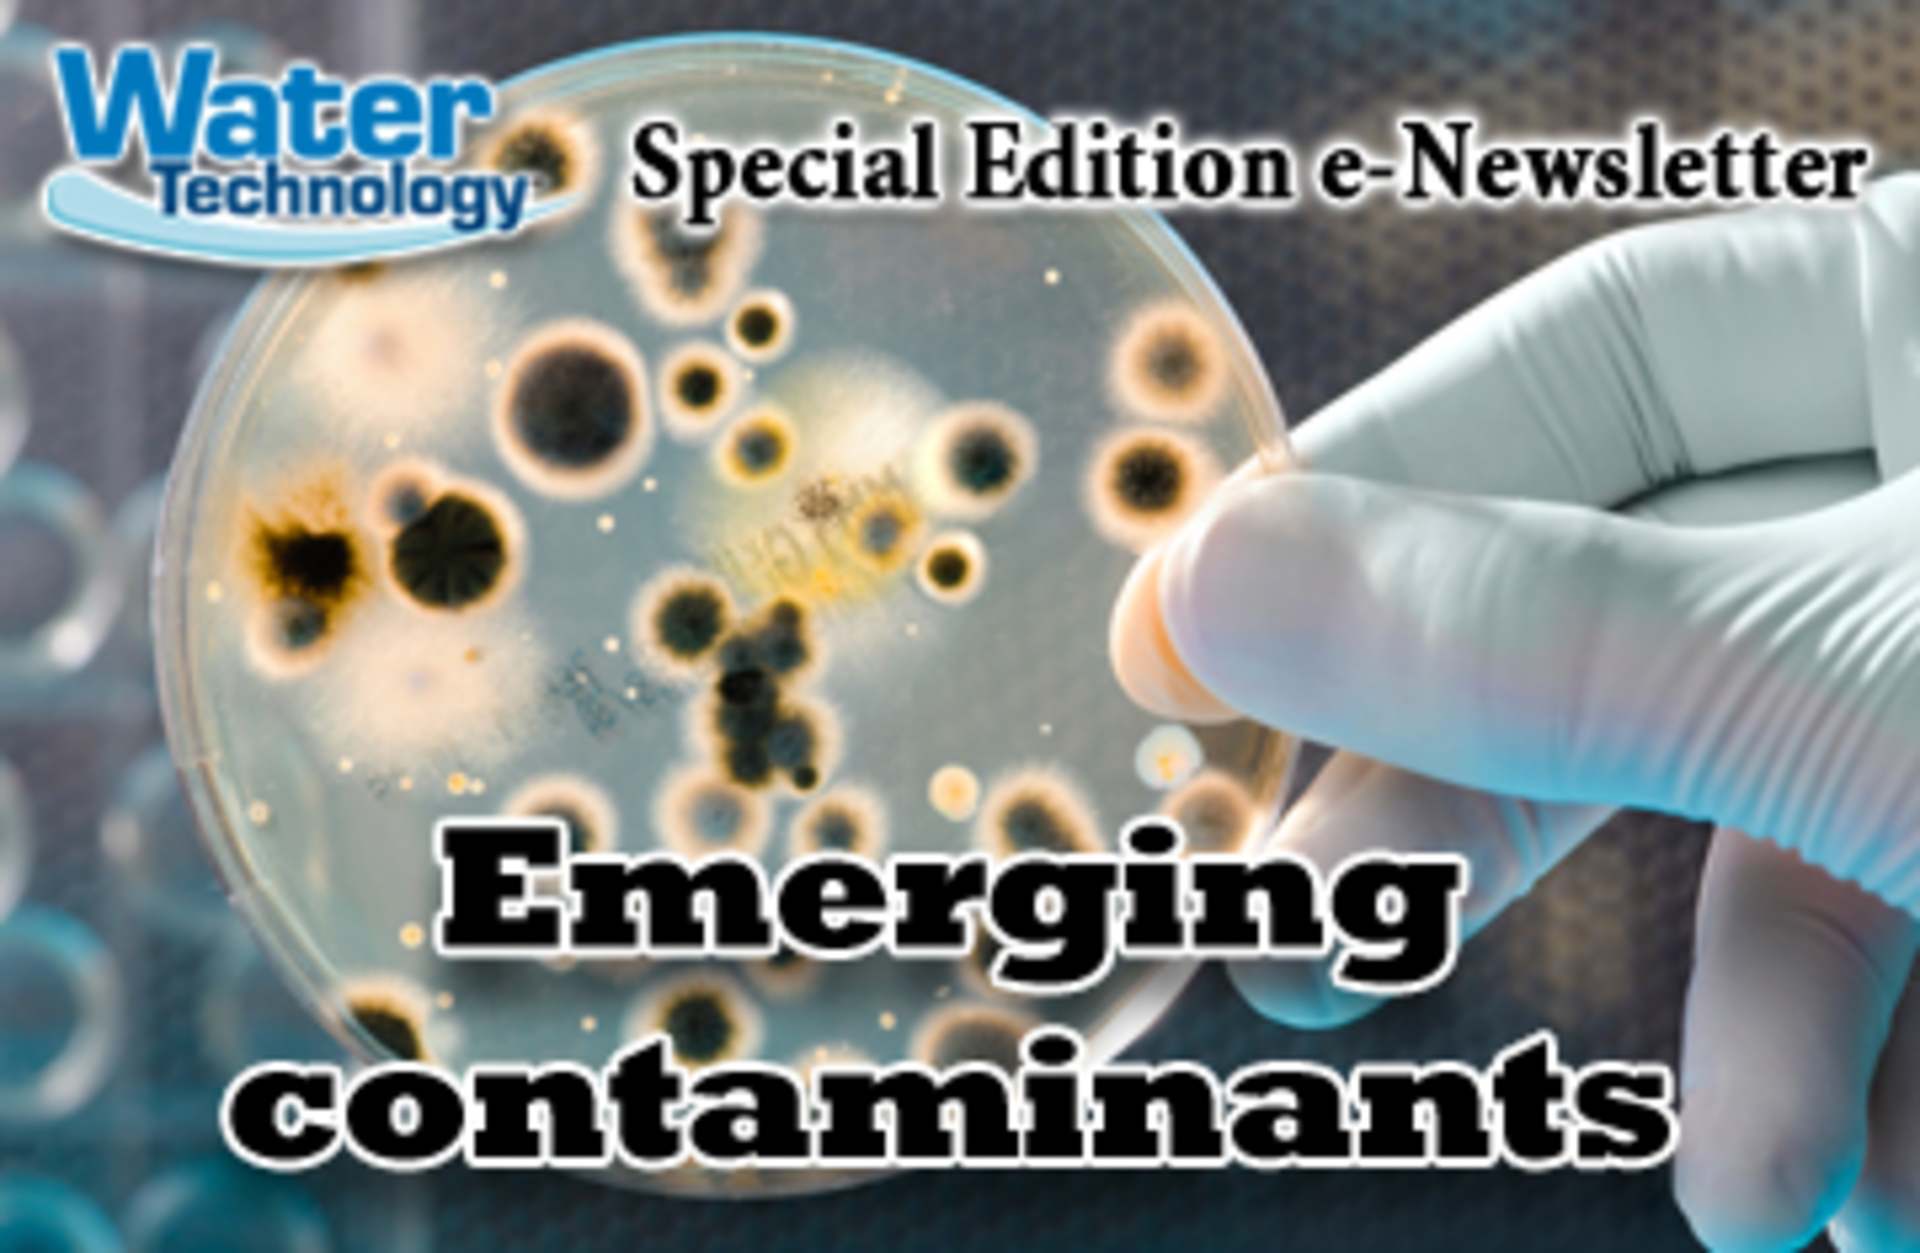
WT

Special Topic Newsletter – Emerging contaminants
June 30, 2015
|
Featured Articles
|
The U.S. Environmental Protection Agency (EPA) strives to understand these emerging contaminants and provide guidelines and regulations when needed.
Our technical editor discusses the recent health advisories for algal toxins: microcystins and cylindrospermopsin.
Certain groups can face severe health issues when a water system fails.
Use the sun’s power to reduce costs and increase cash flow.
Emerging contaminants in the news
Recent news articles and press releases highlighting emerging contaminants.
About the Author
Sign up for our eNewsletters
Get the latest news and updates